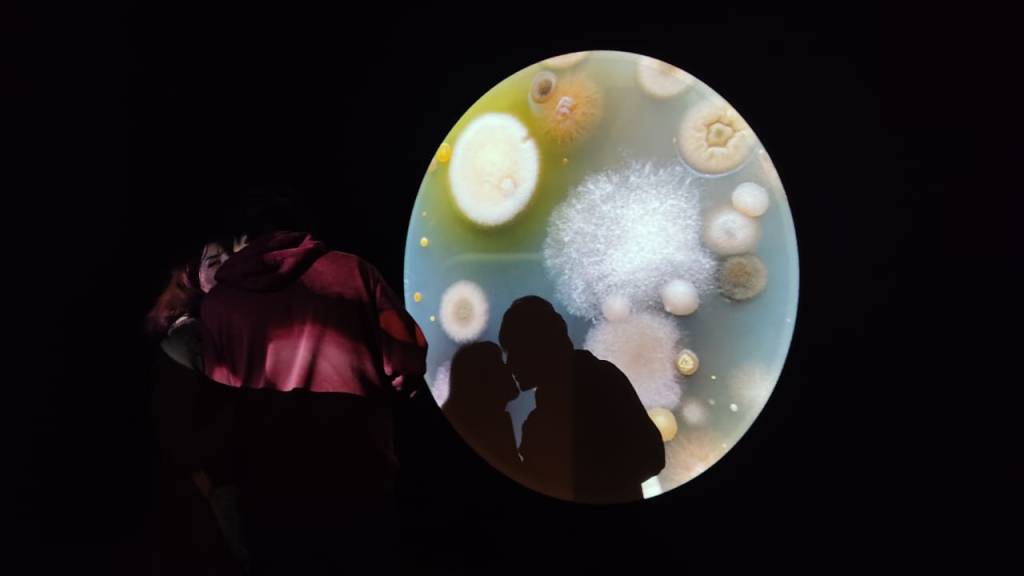

[et_pb_section fb_built=»1″ _builder_version=»4.16″ global_colors_info=»{}»][et_pb_row _builder_version=»4.16″ background_size=»initial» background_position=»top_left» background_repeat=»repeat» global_colors_info=»{}»][et_pb_column type=»4_4″ _builder_version=»4.16″ custom_padding=»|||» global_colors_info=»{}» custom_padding__hover=»|||»][et_pb_text _builder_version=»4.16″ background_size=»initial» background_position=»top_left» background_repeat=»repeat» global_colors_info=»{}»]
La Fundación Museos de la Ciudad le invita este 14 de febrero a enamorarse de los museos. Conéctese con el agua, la ciencia, la historia, la memoria y visite los espacios que conforman la Fundación Museos de la Ciudad: Yaku Parque Museo del Agua, el Museo de la Ciudad, el Museo del Carmen Alto, el Centro de Arte Contemporáneo y el Museo Interactivo de Ciencia.
Disfrute de sus miradores, de sus exposiciones, de sus corredores y de la posibilidad de encontrarse entre amigos, entre vecinos, con su pareja, con sus hijos y con sus nietos en tanto, estos increíbles y encantadores lugares turísticos e históricos de Quito, le brindarán propuestas diferentes para compartir con sus seres queridos.
En Yaku Parque Museo del Agua, de 08h00 a 16h00, descubra el sendero ecológico Pumamaki, una restauración ecológica en la cual podrá disfrutar de la naturaleza y su relación con el agua. Un espacio, refugio de flora y fauna del Distrito Metropolitano de Quito, ideal para caminar y conectar todos sus sentidos mientras se rencuentra con los ecosistemas. Sumérjase en este entorno, con el valor de su entrada al museo.
En el Museo Interactivo de Ciencia, con el pago de su entrada, de 08h00 a 16h00, experimente y diviértase con diferentes conceptos relacionados a la gravedad, la resistencia estructural y la simetría, siendo parte de diversos desafíos y retos que harán que este día sea algo diferente en la sala “Ciencia y Juego: EstructurAndo”
En el Museo del Carmen Alto, de 8h30 a 15h45 sea parte de “Museo a la Carta”, una aventura que le llevará a profundizar las exposiciones permanentes y temporales del espacio mediante recorridos mediados especiales donde conocerá diversas temáticas que se vinculan al arte, el patrimonio, las comunidades, la historia y mucho más. La actividad se incluye con el pago de su entrada al museo.
El Museo de la Ciudad Museo de la Ciudad, le espera a las 18h00 con ¿Qué onda con el amor? Una velada artística y lúdica, con degustación de dulces, para explorar las emociones y los sentimientos que el amor despierta desde su vivencia en la ciudad hasta su influencia en nuestras relaciones cotidianas. Inscríbase a través del siguiente formulario: https://forms.office.com/r/dpDV71XpY8 ; la actividad tiene un valor de USD 4,00 adultos, USD 2,00 estudiantes.
Para el sábado 15 de febrero, a las 19h00, La Nube Casa Cultural, en colaboración con el Centro de Arte Contemporáneo, presentan “Kiki Ballazo al corazón«, un tributo vibrante y audaz al legado trans en Ecuador. Más que una competencia, un espacio de encuentro donde la comunidad celebra su autenticidad, su amor propio y su expresión más genuina. Con seis categorías OTA que incluyen baile, pasarela y moda, este evento invita a liberar la creatividad alrededor de San Valentín/San Violentín /Sin Valentín, en un escenario único. Puede adquirir sus entradas ingresando al siguiente enlace: https://bit.ly/42dbtmC .
Para finalizar la agenda que se activa en los Museos de Quito, en el marco del Día del Amor y la Amistad, el domingo 16 de febrero, de 11h00 a 13h30, apúntese en “Okupar los afectos”, en el Centro de Arte Contemporáneo. Este laboratorio de experimentación artística y deconstrucción del amor romántico busca sensibilizar sobre la anarquía relacional para inventar, habitar y cuidar relaciones más libres. Aquí se podrá adicionalmente crear un fanzine como catálogo de las emociones. El acceso es libre.
[/et_pb_text][/et_pb_column][/et_pb_row][/et_pb_section]

